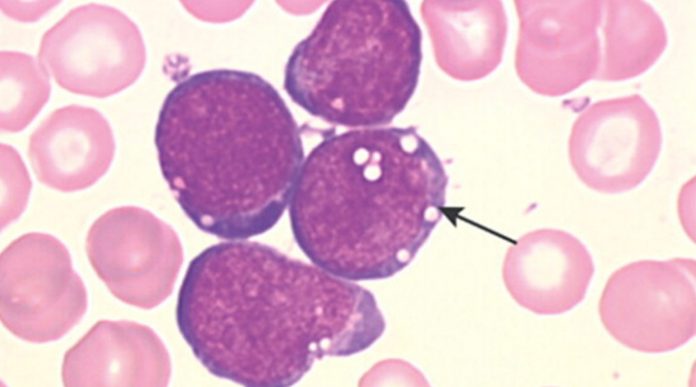
leucemia

Pacientes pediátricos con leucemia linfoblástica aguda hipodiploide no deberían recibir alotrasplante de células hematopoyéticas para tratar de abatir su pronóstico desfavorable.
El Dr. Pui y cols., del Department of Oncology, en el St. Jude Children’s Research Hospital, en Tennessee, Estados Unidos, analizaron datos de más de 300 pacientes con leucemia linfoblástica aguda hipodiploide tratados durante un periodo de 16 años.
En el estudio se encontró que la sobrevida libre de eventos a 5 años fue de solo un poco más de 55%, mientras que la sobrevida global a 5 años fue un poco superior a 61%.
Aunque factores tales como sin enfermedad residual mínima al final de la inducción, número cromosómico de enfermedad y tratamiento dirigido a la enfermedad residual mínima se vincularon a mejores desenlaces, el alotrasplante no confirió beneficio para la sobrevida, en comparación con la quimioterapia sola.
En el estudio, Outcome of Children With Hypodiploid Acute Lymphoblastic Leukemia: A Retrospective Multinational Study, publicado en la versión electrónica de Journal of Clinical Oncology el 18 de enero, se llegó a la misma conclusión incluso al analizar a pacientes sin enfermedad residual mínima.
Los investigadores defienden que si bien los resultados revelan que desde el punto de vista estadístico el alotrasplante no tuvo beneficio en ningún subgrupo de pacientes, no excluye del todo la utilidad del mismo.
Sin embargo, para recomendarlo debería mejorar significativamente el pronóstico con un amplio margen, ya que el proceso de trasplante implica que los pacientes se sometan a radiación (en preparación para recibir el trasplante) y esto les plantea un riesgo de por vida para desarrollar un segundo cáncer.
Con el fin de evaluar la eficacia de las opciones terapéuticas disponibles, los autores llevaron a cabo un análisis retrospectivo de 272 pacientes con leucemia linfoblástica aguda hipodiploide de hasta 21 años de edad, reclutados en los protocolos de 16 grupos de estudio cooperativo o centros individuales entre 1997 y 2013.
Todos los pacientes fueron reclutados en protocolos intensivos y 47 recibieron alotrasplante. La mediana de edad fue de 9,8 años.
Cuarenta pacientes, incluidos cinco que recibieron alotrasplante, tuvieron hipodiploidía considerable con 44 cromosomas.
La ausencia de enfermedad residual mínima, definida como < 10-4, se identificó en 87 de 161 pacientes valorables, mientras que 25 tuvieron enfermedad residual mínima de entre 10-4 y 10-3, y 49 de ≥ 10-3.
Cuatro pacientes fallecieron durante la inducción de la remisión y los 268 restantes lograron una remisión completa.
Durante una mediana de seguimiento de 6,6 años, 90 pacientes presentaron recaída y 24 fallecieron a una mediana de tiempo de 8 meses después de la primera remisión. En la última evaluación, 150 pacientes se mantuvieron en remisión completa continua.
El equipo calculó que la sobrevida libre de eventos a los 5 años fue de 55,1% y la sobrevida global a 5 años de 61,2%.
Después de la recaída la sobrevida fue muy desfavorable: sobrevida a 2 años de 12%.
En el análisis univariable, la ausencia de enfermedad residual mínima se asoció a un desenlace más favorable, a una sobrevida libre de eventos a 5 años de 75%.
Asimismo, la hipodiploidía considerable con 44 cromosomas se asoció a una sobrevida libre de eventos a 5 años, de 74%, mientras que protocolos de tratamiento estratificados según enfermedad residual mínima se vincularon a una sobrevida libre de eventos a 5 años, de 62%.
Para determinar el efecto del trasplante en la sobrevida, el equipo excluyó a los 40 pacientes con alta hipodiploidía con 44 cromosomas, ya que no se les ofreció este tratamiento.
El equipo determinó que la sobrevida libre de eventos ajustada a 5 años no fue significativamente diferente entre los 186 pacientes tratados solo con quimioterapia y los 42 que recibieron trasplante: 53% frente a 59,8% (p = 0,47). Tampoco hubo diferencia en la sobrevida global a 5 años ajustada entre los dos grupos: 57,7% y 68,9%, respectivamente (p = 0,21).
Los investigadores tampoco encontraron diferencia significativa entre quimioterapia sola y trasplante por lo que respecta a la sobrevida libre de eventos a 5 años en pacientes sin enfermedad residual mínima (p = 0,81) y en aquellos con enfermedad residual mínima (p = 0,29).
Medscape.